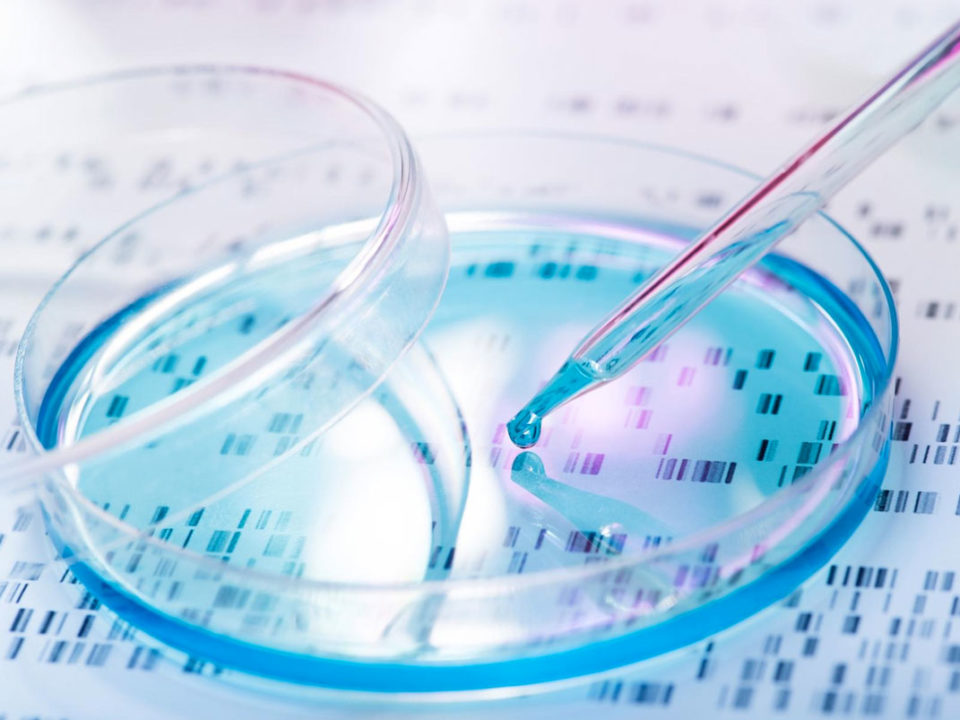
Genetic test

agosto 15, 2019
El análisis de semen, conocido también como recuento espermático es una de las pruebas de fertilidad más comunes que ayudan a determinar si un hombre tiene […]
agosto 7, 2019
Cuando se presenta la infertilidad en una pareja se debe acudir a una clínica de fertilidad para que los especialistas puedan evaluar el caso y recomendar […]
agosto 2, 2019
La lactancia materna es la mejor forma de aportarle a los bebés los nutrientes que necesitan para tener un crecimiento y desarrollo saludable. La OMS y […]
julio 25, 2019
Una de las señales que deben tomar en cuenta para saber si necesitan acudir a una clínica de fertilidad es cuando después de un año intentando […]
julio 17, 2019
La gran mayoría de las parejas suelen tener el deseo de tener un bebé en casa y comienzan con los planes para lograr un embarazo, pero […]